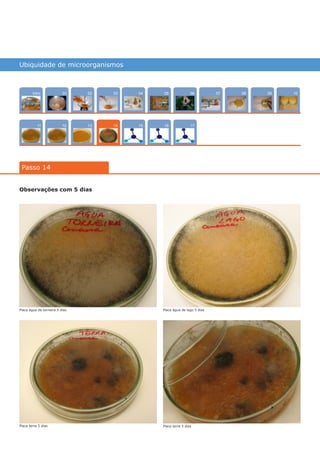
Ubiquidade de microorganismos
Intro
1211
100704
15
02
13
0805
16
03 0906
17
01
Passo 14
14
Observações com 5 dias
Placa água de torneira 5 dias
Placa terra 5 dias Placa terra 5 dias
Placa água de lago 5 dias
várias experiências, um só lugar
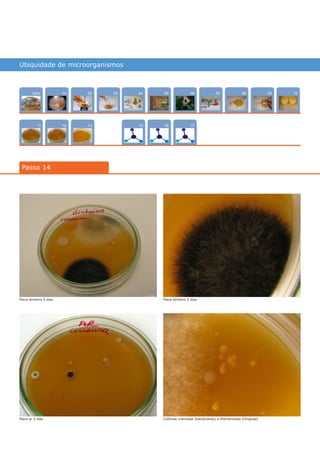
Ubiquidade de microorganismos
Intro
1211
100704
15
02
13
0805
16
03 0906
17
01
Passo 14
Placa dinheiro 5 dias
Placa ar 5 dias
Placa dinheiro 5 dias
Colônias cremosas (bacterianas) e filamentosas (fúngicas)
várias experiências, um só lugar
14

Este documento apresenta um experimento para pesquisar a presença de microorganismos em diversos ambientes através de culturas em placas de Petri. O experimento inclui a preparação do meio de cultura, coleta e inoculação de amostras de solo, água, ar e objetos, e observação do crescimento de colônias após 24 horas, 48 horas e 5 dias.